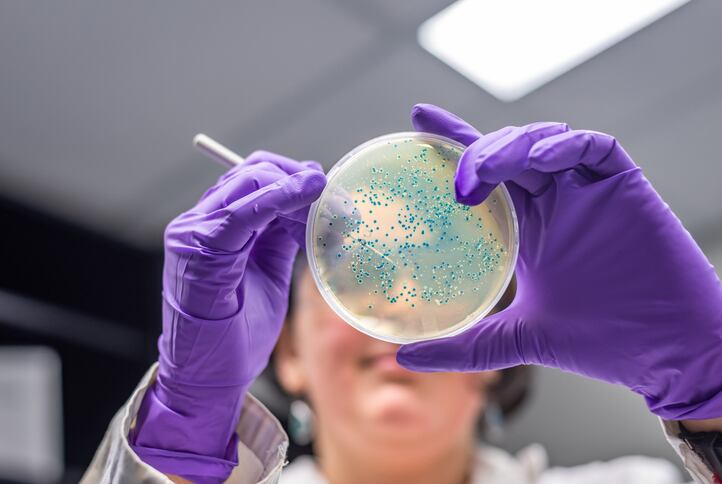

The product, called Ready, Set, Food!, pitched its concept on a segment of the ABC series that aired yesterday. Investor Mark Cuban, who among other things owns the Dallas Mavericks of the NBA, invested $350,000 into the startup.
"Food allergies are a growing problem across the world. I'm excited to partner with Ready, Set, Food! to start to reverse this growing epidemic and make families lives better," said Cuban.
The supplement was developed by a team of physicians. The group included Dr. Gary Rachelefsky, the past president of the American Academy of Allergy, Asthma, and Immunology, and Dr. Jonathan Spergel, MD, Chief of Allergy at Children's Hospital of Philadelphia.
The supplement system is based on just three ingredients: organic cow’s milk, cooked organic egg white and organic peanuts. The supplement starts with a trace and then slightly larger amount of cow’s milk in the ‘Days 1&2’ and ‘Days 3&4’ sachets, then adds the egg white. The system then adds the peanuts, culminating in a ‘maintenance’ formula starting at day 11 of the intervention.
Research supports approach, company asserts
The company claims there are three clinical trials supporting the effectiveness of the supplement system at suppressing the development of common food allergies. The developers say the supplement is not meant for infants who have been diagnosed with a food allergy.
The company also notes the approach is supported by a qualified health claim approved by FDA in 2015 that shows that early childhood introduction of peanuts reduces the chances of developing a peanut allergy later in life by 80%.
"For early food allergen introduction to be protective, infants need regular exposure to the allergen for many months," said Dr. Katie Marks-Cogan, MD, on of the company’s co-founders. "It's important to remember that all babies are at risk of developing food allergies, and there is a window of time to act. Ready, Set, Food! makes it easy to provide safe and sustained exposure to the top three food allergens, which is the best way to reduce a baby's risk of developing food allergies.”
Developing dietary supplements to help deal with the food allergy issue has been a hot category within the supplement industry. Last year, food industry giant Nestlé closed a deal with Before Brands, a company that markets a food allergy suppression supplement called SpoonfulOne. That supplement is aimed at 16 different food allergies and is based on research done at Stanford University. In the deal, announced in September, Nestlé acquired the rights to market the supplement outside the United States and an option to acquire the entire business. Financial terms of the deal were not disclosed.